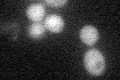
YLR011W
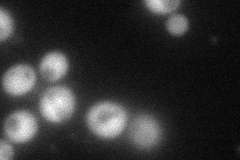
YLR011W
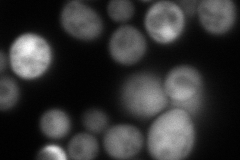
YLR011W
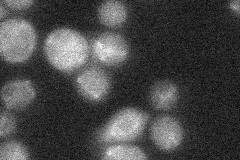
YLR011W
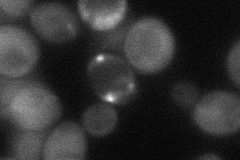
YLR011W
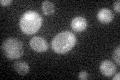
YLR011W

View description
FMN-dependent NAD(P)H:quinone reductase, may be involved in quinone detoxification; expression elevated at low temperature; sequesters the Cin5p transcription factor in the cytoplasm in complex with the proteasome under reducing conditions
Localization:
Intensity:
Fold change:
Significance:
-
C’ GFP library in SD
cytosol26.72 -
N' NOP1pr-GFP in SD
cytosol92.7125 -
N' TEF2pr-mCherry in SD
cytosol158.355 -
N' NATIVEpr-GFP in SD
below threshold20.5647 -
N' TEF2pr-VC and Cyto-VN in SD
cytosol44.2443 -
C’ GFP library in SD+DTT

cytosol28.531.06No -
C’ GFP library in SD+H2O2

cytosol23.180.86No -
C’ GFP library in Starvation Media
cytosol31.531.17No -
C’ GFP library on the background of Pup2-DaMP

cytosol -
C’ GFP library on the background of CCT mutant

cytosol26.26760.982893No
